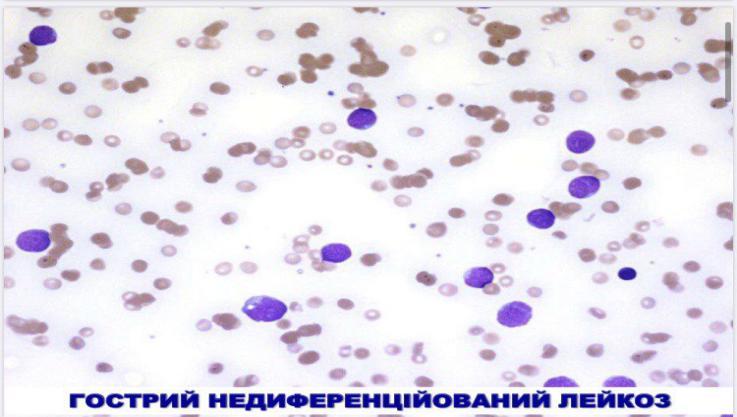

В яких органах зустрічаються аденоми? Їх морфологічна характеристика.
Аденоми - пухлинні поліпи, які варіюють від маленьких пухлин, часто на ніжці, до великих, зазвичай на широкій основі. Доброякісні пухлини, що зазвичай походять із залозистого епітелію.
Місця локалізації можуть бути наступні:
Слинні залози;
Щитоподібна залоза;
Епітелій бронхів;
Молочна залоза;
Слизова оболонка шлунково-кишкового тракту;
Наднирники;
Простата;
Гіпофіз;
Печінка.
Морфологія
Тубулярні аденоми можуть виникнути в будь-якому місці товстої кишки, але приблизно половина їх знайдена в ректосигмоподібному відділі, і пропорція збільшується з віком. Приблизно в половині випадків вони поодинокі, в інших - дві і більше аденоми. Найменші аденоми – ті що стеляться; утворення 0,3 см в розмірі можуть бути ідентифіковані ендоскопічно. У большості більших тубулярних аденом до 2,5 см в діаметрі є тонкі ніжки 1-2см довжиною і подібні малині «головки» . Гістологічно ніжка покрита нормальною товстокишечною слизовою оболонкою, але головка складається з пухлинного епітелію, формуючи гілчасті залози, вистелені високими гіперхромними, дещо безладно розташованими
клітинами, які можуть зберігати чи не зберігати секрецію слизу. У деяких випадках спостерігаються дрібні фокуси ворсинчастої аденоми. У явно доброякісної аденоми розгалужені залози чітко відокремлені особистою пластинкою слизової оболонки і рівень дисплазії або цитологічної атипії є незначним. Однак в аденоматозних поліпах можна виявити всі ступені дисплазії аж до раку на місці, а також раку, обмеженого слизовою оболонкою або інвазивної карциноми, що розповсюджується на підслизовий шар ніжки. Часта знахідка в будь-який аденомі - поверхнева ерозія як наслідок механічної травми.
Ворсинчасті аденоми - більші і небезпечні епітеліальні поліпи. Вони частіше спостерігаються у літніх осіб в прямій кишці і ректосігмоподібному відділі, але можуть бути знайдені і в інших місцях. Вони зазвичай сланкі, до 10см в діаметрі, оксамитові або подібні цвітній капусті маси, набухали на 1-3см над навколишньою нормальною слизовою оболонкою. Гістологічно розгалужені ворсінча ті відростки слизової оболонки покриті диспластичним, іноді безладним циліндричним епітелієм. Всі ступені дисплазії можуть бути знайдені, і частота інвазивної карциноми, що спостерігається в 40% цих аденом, корелює з розміром поліпа.
Тубулярно-ворсинчасті аденоми досить різні.За частотою наявності ніжки, розміром, ступенем дисплазії і ризику прихованої внутрішньослизової або інвазивної карциноми вони займають проміжне положення між тубулярноюі ворсинчатою аденомами.
В яких органах зустрічаються менінгіоми? Їх морфологічна характеристика.
Менінгіоми, як правило, доброякісні пухлини, що виникають у дорослих. Незважаючи на те, що пухлини з‘являються з менінготеліальних клітин павутинної оболонки, вона зазвичай спаяна з твердою мозковою оболонкою. Менінгіоми можуть розташовуватися по всій зовнішній поверхні головного мозку, а також в шлуночковій системі (джерело - стромальні клітини судинного сплетення).
Морфологія
Менінгіоми, спаяні з твердої мозкової оболонкою, - чітко відмежовані маси, здавлюють головний мозок, але легко відокремлюються від нього. Іноді пухлини проростають в кістки черепа. Менінгіоми представлені різними гістологічними варіантами:
• синцитіальні - утворення структур у вигляді завитків з кластерів тісно лежачих клітин зі слабо помітними мембранами;
• фібробластичні - пухлинні клітини мають видовжену форму, між ними виявляють велику кількість колагенових волокон;
• перехідні - властивості як фібробластичного, так і синцитіального варіантів;
• псамоматозні - численні псаммоматозні (псамозні) тільця;
• секреторниі- в цитоплазмі пухлинних клітин містяться вакуолі, які виявляються за допомогою PAS-реакції і електронної мікроскопії;
• мікрокістозна - макроскопічно пухлина має пухку, губчасту будова.
Атипові менінгіоми, крім гістологічних особливостей (більш висока мітотична актив- ність), відрізняє схильність до розвитку рецидивів і агресивні локальні зростання, що визначає необхідність в комплексному лікуванні. Анапластична (злоякісна) менінгіома - вкрай агресивна пухлина, за гістологічною структурою нагадує низькодиференційовану саркому. Проте, зазвичай зберігаються гістологічні ознаки, що вказують на менінгосудинне походження пухлини.
В яких органах зустрічаються карциноїди? Їх морфологічна характеристика в залежності від ступеня злоякісності.
Клітини, що генерують біоактивні речовини, особливо пептидні і непептідні гормони, зазвичай знаходяться уздовж слизової оболонки шлунково-кишкового тракту і грають важливу роль в скоординованій функції шлунково-кишкового тракту. Ендокринні клітини рясніють в інших органах, але більшість пухлин, що розвиваються з цих клітин, виникає в кишці. Пухлини, що походять з цих ендокринних клітин, називаються карциноїднимм пухлинами; вони можуть розвинутися в підшлунковій залозі або періпанкреатичнцй тканині, легенів, білі- арному дереві і навіть печінки.
Морфологія
Апендикс - найбільш поширена зона кишкових карциноїдних пухлин, поступається тонкій кишці (перш за все клубової), прямій кишці, шлунку і товстій кишці. У аппендиксі вони з'являються як цибулеподібне потовщення кінця, з часто облітерірованим просвітом. У других місцях шлунково-кишкового тракту вони з'являються як інтрамуральні або підслизові маси, створюють дрібні, поліпоїдні або подібні плато піднесення, рідко перевищують 3 см в діаметрі. Прилегла слизова оболонка може бути непошкодженою або вилучена, і пухлини можуть проникать в стінку кишечника, інвазуючи брижі. Ті, що виникають в шлунку і клубової кишці, часто є багатополюсними, але інші мають тенденцію бути поодинокими ушкодженнями. Характерна ознака - щільний, жовто-коричневий вид на розрізі. Пухлини надзвичайно щільні через десмоплазіі; і коли ці фіброзуючі пошкодження проникають через брижі тонкої кишки, вони можуть викликати перегин або зігнутість достатню, щоб викликати обструкцію. Коли присутні вісцеральні метастази - зазвичай дрібні, розсіяні вузли, рідко досягають розміру первинних ушкоджень. Примітно, що ректальні і аппендикулярні карциноїди майже ніколи не метастазують.
Гістологічно пухлинні клітини можуть формувати дискретні острівці, трабекули, тяжі, залози або недиференційовані листи. Безвідносно їх організації пухлинних клітин монотонно схожі, маючи мізерну рожеву грануляційну цитоплазму і кругле або овальне помережане ядро. У більшості пухлин можемо бачити мінімальну варіацію розмірів клітин і ядер, і мітози стають нечастими або відсутні.
В яких органах зустрічаються тимоми? Їх класифікація, з яких клітин вони походять.
Тимоми - група епітеліальних новоутворень, що містять окремі або численні попередники Т-лімфоцитів (тімоціти), які вважають непухлинним компонентом.
К-ція:
• Доброякісна або інкапсульована тимома - цитологічно і біологічно доброякісна.
• Злоякісна тимома
- Тип I – цитологічно доброякісна,
але клінічно агресивна (здатна до локаль ної інвазії і в окремих випадках до метастазування).
- Тип II (рак тимуса): цитологічно визначають виражену атипию, поведінка відповідає злоякісній пухлині.
Морфологія
Злоякісна тимома I типу (становить 20-25% всіх випадків) - цитологічно доброякісна пухлина з місцевим деструктивним ростом, іноді непередбачувано метастазує. Складається з епітеліальних клітин і реактивних тимоцитов, співвідношення яких варіює; перші зазвичай нагадують кортикальні елементи і мають добре розвинену цитоплазму і округлі везикулярні ядра. Неопластичні епітеліальні клітини часто формують палісадні структури навколо кровоносних судин, деякі можуть мати веретеноподібну форму. Основний діагностичний критерій- проростання капсули і інвазія навколишніх тканин.
Загальноприйняте позначення злоякісної тимоми II типу - рак тимуса. Частка цієї пухлини становить приблизно 5% всіх тимом; на відміну від I типу, виявляють цитологічні ознаки злоякісності Макроскопічно зазвичай являє собою пухкі маси, що проростають в навколишні структури, іноді метастазує (наприклад, в легені). Будова пухлини зазвичай нагадує високо- або низькодиференційований плоскоклітинний рак. Наступна по розповсюдженню злоякісна пухлина - лімфоепітеліальний рак, представлений анапластичними епітеліальними клітинами кортикального типу в поєднанні з численними нормальними тимоцитами. Дана пухлина найбільш поширена в країнах Азії, іноді поєднується з носійство вірусу Епштейна-Барр.
В яких органах зустрічаються гліобластоми? Їх морфологічна характеристика.
Гліобластома - це злоякісна пухлина, яка розвивається з клітин нервової системи, специфічної оболонки нервових волокон, і локалізується в тканинах головного мозку.
Морфологія
Зовні фібрилярна астроцитома має вигляд інфільтруючих пухлини сірого кольору з нечіткими межами, яка здавлює і деформує мозок, одночасно проростаючи в нього. Завжди відзначається інвазія за межі зовнішньо видимого кордону. На розрізі пухлина має щільну або м'яку консистенцію; можуть виявлятися кісти.
Для гліобластоми характерна неоднорідність будови. Одні ділянки пухлини щільні, білого кольору, інші - м'які і жовті (внаслідок некрозу), по-третє виявляють кісти і крововиливи.
З яких клітин походить меланома, її класифікація.
Меланома розвивається з клітин нейрогенного походження (атипових меланоцитів) клітини, що виробляють мелатонін.
Класифікація меланом:
Злоякісна меланома.
Злоякісна меланома, яка виникла з передракового меланозу, Включаючи меланотичну пляму Гетчинсона.
Злоякісна меланома, яка виникла з голубого невуса.
Злоякісна меланома, що виникла з велетенського пігментного невуса.
Які дві групи раку легень існують в залежності від гістогенезу пухлини?
Перша група епітеліальні пухлини – тобто карциноми:аденокарцинома, плоскоклітинний рак, недиференціальний рак).
Друга група нейроєндокринні пухлини – сюди відносяться дрібноклітинний та великоклітинні пухлини.
Враховуючи принцип гістологісної класифікації назвіть первинні пухлини селезінки.
До первинних пухлин селезінки, враховуючи принципи гістологічної класифікації, відносяться:
Ліпома
Гемангіома
Гемлімфангіома
Гемангіоендотеліома
Лімфангіома
Кістозна лімфангіома
Лімфома неходжкінська
Лімфома Ходжкіна
Мезенхіома
Плоскоклітинний рак
Злоякісна не диференційована пухлина
Враховуючи принцип гістологічної класифікації назвіть первинні пухлини легень.
До первинних пухлин легень, враховуючи гістологічну класифікацію, відносяться:
Дрібноклітинний рак легень
Вівсяноклітинний рак
Проміжковоклітинний рак
Комбінований рак
Недрібноклітинний рак легень
Аденокарцинома
Ацинарна
Бронхіолоальвеолярний
Папілярний
Солідний
Аденосквамозний
Великоклітинний
Світлоклітинний
Гігантоклітинний
Сквамозні клітини
Веретеноклітинний
Враховуючи принцип гістологічної класифікації назвіть первинні пухлини печінки.
До первинних пухлин печінки, враховуючи гістологічну класифікацію, відносяться:
Епітеліальні гепатоцелюларні доброякісні пухлини :
Гепатоцеллюлярная аденома
Фокальная нодулярная гіперплазія
Злоякісні гепатоцеллюлярні пухлини:
гепатоцелюларний рак
гепатоцеллюлярний рак (фіброламеллярний варіант)
гепатобластома, епітеліальні варіанти
недифференційований рак
Холангіокарцинома
Ангіосаркома
Цистаденокарцинома
Враховуючи принцип гістологічної класифікації назвіть первинні пухлини шкіри.
До первинних пухлин шкіри, враховуючи принцип гістологічної класифікації, відносяться:
I. Базальноклітинна карцинома:
– поверхнева;
– вузлова (солідна);
– мікровузлова;
– інфільтративна;
– фіброепітеліальна;
– з придатковим диференціюванням;
– базальноплоскоклітинна карцинома з ороговінням.
II. Плоскоклітинна карцинома:
– акантолітична;
– веретеноклітинна;
– верукозна;
– псевдосудинна;
– аденоплоскоклітинна.
Враховуючи принцип гістологічної класифікації назвіть первинні пухлини кісток.
До первинних пухлин кісток, враховуючи принцип гістологічної класифікації, відносяться:
І. Хрящоутворюючі пухлини.
А. Доброякісні:
1) хондрома;
2) хондробластома;
3) остеохондрома (кістково-хрящовий екзостоз);
4) хондроміксоїдна фіброма.
Б. Злоякісні:
1) юкстакортикальна хондросаркома;
2) мезенхімальна хондросаркома;
3) хондросаркома.
II. Кістковооутворюючі пухлини.
А. Доброякісні:
1) остеома, остеоїд-остеома та остеобластома (остеобластокластома).
Б. Злоякісні:
1) остеогенна саркома;
2) юкстакортикальна остеосаркома (паростальна).
ІІІ. Гігантоклітинна пухлина (остеокластома).
А. Доброякісна.
Б. Злоякісна.
IV. Кістковомозкові пухлини.
А. Саркома Юінга.
Б. Ретикулосаркома кістки.
В. Лімфосаркома кістки.
Г. Мієлома.
V.Судинні пухлини.
А. Доброякісні:
1) гемангіома;
2) лімфангіома;
3) гломусна пухлина.
Б. Проміжні:
1) гемангіоендотеліома;
2) гемангіоперицитома.
В. Злоякісні:
1) ангіосаркома.
VI. Інші сполучнотканинні пухлини.
А. Доброякісні:
1) фіброма;
2) ліпома.
Б. Злоякісні:
1) ліпосаркома;
2) фібросаркома;
3) злоякісна мезенхімома;
4) недиференційована саркома.
VIІ. Інші пухлини.
А. Хордома.
Б. Нейрофіброма.
В. Неврилемома (шванома, невринома).
Г. Нейрофіброма.
VIII. Некласифіковані пухлини.
IX. Пухлиноподібні ураження.
Враховуючи принцип гістологічної класифікації назвіть первинні пухлини апендикса.
До первинних пухлин апендикса, враховуючи принцип гістологічної класифікації, відносяться:
1.Нейроендокринна пухлина:
-карциноїд;
2.Нейроендокринний рак:
-великоклітинний;
-дрібноклітинний;
3.Змішаний залозисто-нейроендокринний рак;
4.Цистаденокарцинома:
-неінвазивна;
-папилярно-муцинозна;
5.Муцинозні новоутворення
Враховуючи принцип гістологічної класифікації назвіть первинні пухлини підшлункової залози.
До первинних пухлин підшлункової залози, враховуючи принцип гістологічної класифікації, відносяться:
І. Епітеліальні пухлини
Доброякісні:
- Ацинарноклітинна цистаденома;
- Серозна цистаденома;
Передзлоякісні зміни підшлункової залози:
- Панкреатична інтраепітеліальна неоплазія 3 ступеня (PanIN-3);
- Внутрішньопротокова папілярна муцинозна пухлина з легкою чи помірновираженою дисплазією;
- Внутрішньопротокова папілярна муцинозна пухлина з тяжкою дисплазією;
- Внутрішньопротокова тубулопапілярна пухлина;
- Муцинозна кістозна пухлина з легкою чи помірновираженою дисплазією;
- Муцинозна кістозна пухлина з тяжкою дисплазією;
Злоякісні:
- Протокова аденокарцинома;
- Аденоплоскоклітинний рак;
- Колоїдний рак (муцинозний некістозний рак);
- Гепатоїдний рак;
- Медулярний рак;
- Перснеподібний рак;
- Недиференційований рак;
- Ацинарноклітинна карцинома;
- Ацинарноклітинна цистаденокарцинома;
- Внутрішньопротокова папілярна муцинозна пухлина асоційована з інвазивним раком;
- Змішаний ацинарно-протоковий рак;
- Змішаний ацинарно-нейроендокриний рак;
- Змішаний ацинарно-нейроендокринно-протоковий рак;
- Панкреатобластома;
- Серозна цистаденокарцинома;
ІІ. Нейроендокринні пухлини:
- Нейроендокринна мікроаденома підшлункової залози;
- Нейроендокринная пухлина;
- Нейроендокринний рак:
- Великоклітинний нейроендокринний рак;
- Дрібноклітинний нейроендокринний рак;
- EC-клітинна, серотонінпродукуюча нейроендокрина пухлина (карциноїд);
- Гастринома;
- Глюкагонома;
- Інсулінома;
- Соматостатинома;
ІІІ. Зріла тератома;
ІV. Мезенхімальні пухлини;
V. Лімфоми;
VI. Вторинні пухлини.
Враховуючи принцип гістологічної класифікації назвіть первинні пухлини спинного мозку.
До первинних пухлин спинного мозку, враховуючи принцип гістологічної класифікації, відносяться:
1. Інтрамедулярні пухлини:
- гліоми;
- епендимоми;
- астроцитоми
2. Екстрамедулярні пухлини:
Інтрадуральні:
менінгіоми;
нейрофіброми;
Екстрадуральні:
карциноми легень, молочних залоз, передміхурової залози, нирок, щитоподібної залози;
лімфомы (неходжкінські лімфоми, лімфома Ходжкіна, лімфосаркоми, ретикулоклітинні саркоми).
Враховуючи принцип гістологічної класифікації назвіть первинні пухлини головного мозку.
До первинних пухлин спинного мозку, враховуючи принцип гістологічної класифікації, відносяться пухлини нейроектодермального походження, а саме:
астроцитарні пухлини (астроцитоми, астробластоми);
олігодендрогліальні пухлини (олігодендрогліома, олігоденробластома);
епендимальні пухлини і пухлини хоріоїдного епітелію (епендимома хоріоїдна папілома, епиндимобластома, хоріоїдкарцинома);
нейрональні пухлини (гангліоневрома, нейробластома, гангліонейробластома);
низькодиференційовані та ембріональні пухлини (медулобластома, гліобластома);
менінгосудинні пухлини (менінгіома, менінгіальна саркома);
Що таке цистаденома, в яких органах зустрічається?
Цистоаденома:
доброякісна епітеліальна пухлина;
макроскопічно вони мають вигляд кісти;
розміри пухлини різні — від декількох міліметрів до декількох десятків сантиметрів.
капсула пухлини представлена щільною волокнистою сполучною тканиною;
епітелій, який вистилає внутрішню стінку, найчастіше однорядний кубічний або плоский, рідше — циліндричний.
розрізняють кісти:
— однокамерні (однопорожнинні);
— багатокамерні (багатопорожнинні).
Залежно від стану внутрішньої вистилки кісти бувають:
— гладкостінні;
— сосочкові, або папілярні (сосочкові випинання епітеліальної вистилки всередину порожнини).
За характером вмісту кісти ділять на:
— серозні;
— муцинозні, які виробляють слиз (муцин).
найчастіше зустрічаються ц. яєчника, також печінки ( біліарна ц.), рідше підшлункової залози.
Дайте визначення пухлини. Класифікація пухлин.
Пухлина – це типовий патологічний процес, при якому відбувається безмежний та нерегульований поділ клітин.
Принципи класифікації пухлин:
За клінічним перебігом всі пухлини діляться на:
доброякісні пухлини - зрілі, вони ростуть експансивно, не інфільтрують навколишню тканину, формуючи псевдокапсулу із здавленої нормальної тканини та колагену, в них переважає тканинний атипізм, не метастазують.
злоякісні пухлини - незрілі, ростуть інфільтративно, переважає клітинний атипізм, метастазують.
Гістогенетичний — заснований на визначенні належності пухлини до певного тканинного джерела розвитку. У відповідності з цим принципом розрізняють пухлини:
епітеліальної тканини;
сполучної тканини;
м’язової тканини;
судин;
меланінутворюючої тканини;
нервової системи та оболонок мозку;
системи крові;
тератоми.
Гістологічний за ступенем зрілості (згідно класифікаціям ВООЗ) — в основу класифікації покладений принцип вираженості атипії. Зрілі пухлини характеризуються домінуванням тканинного атипізму, незрілі - клітинного.
Онконозологічний — згідно Міжнародній класифікації хвороб.
За поширеністю процесу — міжнародна система TNM, де Т (tumor) — характеристика пухлини, N (nodus) — наявність метастазів у лімфатичних вузлах, М (metastasis) — наявність віддалених метастазів.
Дайте визначення раку. Гістологічна характеристика раку.
Рак — це незріла, злоякісна пухлина з епітелію. Рак можуть розвиватися з покривного та із залозистого епітелію.
Основна класифікація раків заснована на гістологічній картині, яку копіює паренхіма пухлини.
Розрізняють наступні раки з покривного епітелію:
плоскоклітинний зроговілий рак;
плоскоклітинний незроговілий рак;
базальноклітинний рак;
недиференційований рак (дрібноклітинний, поліморфноклітинний);
перехідно-клітинний рак.
Крім того, зустрічаються змішані форми раку, які складаються з двох видів епітелію (плоского і циліндричного), вони називаються диморфні раки.
Класифікація раків із залозистого епітелію:
аденокарцинома;
солідний рак;
слизовий (колоїдний) рак (його різновид — персневидно-клітинний рак).
Додаткова класифікація раків заснована на співвідношенні паренхіматозного та стромального компонентів пухлини, у зв’язку з чим розрізняють:
медулярний (мозкоподібний) рак, який характеризується домінуванням паренхіми над стромою. Пухлина м’яка, біло-рожевого кольору, нагадує тканину головного мозку;
простий, або вульгарний рак, який містить приблизно однакову кількість паренхіми і строми;
скір, або фіброзний рак, який відрізняється переважанням строми над паренхімою.
Дайте визначення раку. Цитологічна характеристика раку.
Рак — це незріла, злоякісна пухлина з епітелію. Рак можуть розвиватися з покривного та із залозистого епітелію.
Морфологічні характеристики злоякісних пухлин:
клітинний поліморфізм (варіабельність форми та розмірів);
ядерна гіперхромазія, поліморфізм та підвищення ядерно-клітинного співвідношення (у нормі ядерно-клітинне співвідношення = 1:4-1:6);
втрата нормальної полярності клітин та стратифікації пластів клітин (особливо, у пухлинах епітеліального походження);
Дайте визначення раку. Молекулярно-біологічна характеристика раку.
Рак – це злоякісне новоутворення, яке походить із епітеліальних клітин.
Молекулярно-біологічна характеристика раку:
Автономне забезпечення факторами росту - продукція власних факторів росту, або стимуляція їх виділення в мікрооточення
-мутація генів, що кодують рецептори до факторів росту (мутація або гіперекспресія рецепторів)
-мутації в генах, що кодують сигнальні білки-трансдуктори (найпошереніші RAC та ABL)
-мутація генів, що регулюють транскрипцію ДНК
Нечутливість до інгібіторів росту пухлин:
-RB: регулятор клітинного циклу (ген ретинобластоми)
-ТР53 (кодує протен р53)
-трансформувальний фактор росту-бета
Порушення клітинного метаболізму (ефект Варбурга – перехід на анаеробний гліколіз)
Ухилення від апоптозу (мутації в генах, які контролюють процес апоптозу)
Необмежений реплікативний потенціал (іммортальність)
Підтримувальний ангіогенез
Інвазія і метастазування
Уникнення імунного контролю
Нестабільність геному як умова малігнізації
Пухлинно-асоційоване запалення як умова малігнізації
*Детальніше: Роббінс 1 том ст. 212-237
Які пухлини в структурі захворюваності частіше зустрічаються у дітей? Поясніть чому.
Згідно статистиці до найаоширеніших пухлин у дітей належать:
Гостра лімфоїдна лейкемія та госта мієлоїдна лейкемія –гості лейкемії виникають внаслідок порушення проліферації та диференціації незрілих клітин мієлоїдного та лімфоїдного ростків. Саме у дитячому віці кількість недиференційованих клітин достатньо велика, і більша вірогідність, що ці види пухлин виникнуть під час дитинства.
злоякісні пухлини головного мозку та центральної нервової системи (гліоми головного мозку, епендимоми)
нейробластоми – пухлини, які виникають внаслідок порушення диференціації та проліферації незрілих нервових клітин, проявляють себе у дитячому віці
*Детальніше: https://www.healthychildren.org/English/health-issues/conditions/cancer/Pages/Childhood-Cancer.aspx
Які пухлини в структурі захворюваності частіше зустрічаються у чоловіків? Поясніть чому.
Згідно статистиці до пухлин, що найчастіше виявляють у чоловіків належать:
Рак легень – на даний момент найвпливовішим фактором розвитку раку легень є паління, досить велика частка чоловічої половини населення палить
Аденокарцинома простати – один з факторів ризику розвитку цього виду раку – зменшення секреції андрогенів, які впливають на нормальну проліферацію клітин залози. Це найпоширеніший рак серед чоловіків 50-60 років, у яких зменшується секреція гормонів внаслідок віку
Які пухлини в структурі захворюваності частіше зустрічаються у жінок? Поясніть чому.
Згідно статистиці до пухлин, що найчастіше виявляють у жунок належать:
Рак грудей – один з факторів ризику розвитку цього виду раку – зменшення секреції естрогенів, що необоротньо виникає у жінки з віком
Рак легень - на даний момент найвпливовішим фактором розвитку раку легень є паління, тому це достатньо поширений вид пухлин
Рак шийки матки – до факторів ризику належать паління, інфекції (зокрема вірус папіломи людини)
Від чого залежить ефективність лікування раку? Як можна це прогнозувати патологоанатомічними методами?
Ефективність лікування раку залежить від:
Ранньої діагностики злоякісної пухлини
Типу пухлини
Ступеня злоякісності пухлини на єтапі діагностики
Наявності метастазів пухлини
Схильності пухлини до рецедивів
Загального стану пацієнта
Певні генетичні альтерації пов’язані з несприятливим прогнозом, отже, їх наявність визначає тактику подальшого лікування. Методи FISH та ПЛР застосовують з метою виявлення ампліфікації онкогенів, таких як НЕR2 I NVYC, завдяки чому можна отримати терапевтичну і прогностичну інформацію стосовно карциноми грудної залози та нейробластоми відповідно.
Яким методом можна визначити первинну пухлину при дослідженні біопсії анонімного метастазу?
Імуногістохімічним методом.
Метод заснований на виявленні певних клітинних і позаклітинних антигенів із використанням специфічних моно- і поліклональних первинних антитіл з наступним вивченням їх експресії в мікроскопі.
Лише вони забезпечують специфічну візуалізацію локалізації певного антигену. Імунофенотипові ознаки малігнізації з’являються значно раніше, ніж загальноприйняті гістологічні, що може бути використане для більш достовірного виявлення пухлинного росту та прогнозування рецидиву
Що таке верифікація пухлини, які патологоанатомічні методи та методики використовують?
Верифікація пухлини - це медична процедура, метою якої є перевірка і підтвердження онкологічного діагнозу.
Для морфологічного дослідження використовуються різні методи забору матеріалу:
- Зіскрібки і мазки-відбитки . Є поширеним способом діагностики поверхневих укритих виразками пухлин.
- Пункція. Виконується при поверхнево розташованих вузлових утвореннях. У незрозумілих випадках вдаються до проведення імуногістохімічних , електронно-мікроскопічних досліджень , іноді виявляють додаткові морфологічні ознаки, що дозволяють зіставити пухлина з вихідною тканиною. В даний час при виявленні пухлини внутрішніх органів можливо здійснити морфологічне дослідження практично в будь-якій частині тіла.
- Браш-біопсія. Використовують ендоскопічні методи дослідження: фаринго- і ларингоскопію, езофагогастродуоденоскопія, торакоскопію, бронхоскопію, колоноскопію і ін., В ході яких під візуальним контролем зазвичай забирають ділянку тканини (біоптат або браш-біоптат - зішкріб спеціальною щіточкою, змиви з поверхні освіти і т.д.) для морфологічного дослідження.
- Відкрита біопсія. Виконується, як правило, після невдалих спроб верифікувати діагноз вищевказаними методами або через необхідність отримати більше тканини для виконання деяких специфічних досліджень.
-Трепан-біопсія. Гістологічна верифікація може бути отримана при використанні спеціальної голки, при цьому вилучається стовпчик зміненої тканини, придатний для гістологічного дослідження.
Що таке гістологічне дослідження замороженого зрізу, коли це використовується в клінічній практиці?
Заморожені зрізи часто використовують для імуногістохімічних реакцій, при цьому необхідно уникати нагрівання зрізу тканини, тому для заморожених зрізів використовують спеціальні предметні скла з Полі-L-лізіновим покриттям.
Що таке пухлина Юінга? Визначення, морфологічна характеристика, епідеміологія.
Саркома Юінга - це невеликі пухлини круглої форми, що демонструють різну ступінь нейроектодермальної диференціації. Вони є однією з найпоширеніших пухлин дитячого віку і зустрічаються в кісткових тканинах і в м'яких тканинах.
Макроскопічно:
Біла, м'ясиста, погано визначена пухлина з великим ураженням кісткового мозку та кори із збільшенням періосту
Може бути некротичною або нагадувати гній
Зразки зазвичай випилюють після терапії і виявляють фіброз, крововиливи та некрози
Мікроскопічно:
Пласт невеликих круглих однорідних клітин із мізерною прозорою цитоплазмою, поділеними на неправильні часточки волокнистими нитками
Невиразні клітинні мембрани
Цитоплазма часто має вакуолі глікогену; може бути амфофільним
Круглі ядра з відступами, дрібні ядра
Мінімальна кількість строми
Мало мітозів
Можуть мати великі плеоморфні клітини, органоїдний малюнок, філігранний малюнок (великі ділянки некрозу периваскулярної пухлини з "примарними клітинами")
Атипова саркома Юінга
Цитологічні особливості відрізняються від класичної форми
Обмежена нервова диференціація, але без гістологічно впізнаваних нейронних ознак
Часто містять підвищену кількість строми і можуть здаватися вузловими, навіть до точки, що нагадують альвеолярну рабдоміосаркому
Більше мітозів
Яке значення має йонізувальне випромінювання для формування пухлин? Поясніть його механізм.
Радіація, незалежно від джерела випромінювання (УФ-спектр сонячного проміння, рентгенівські апарати, ядерний розпад, радіонукліди), є канцерогенним агентом із доведеною дією.
Терапевтичне опромінення голови та шиї може стати причиною папілярного раку щитоподібної залози протягом наступних кількох років. Онкогенні властивості йонізувального випромінювання зумовлені його мутагенним впливом: ушкодженням хромосом, перегрупуванням генів, наприклад транслокаціями чи інверсіями, і рідше -точковими мутаціями. З біологічної точки зору, розриви дволанцюгової молекули ДНК вважають найважливішим різновидом ушкоджень ДНК, спричинених радіацією.
Онкогенний ефект УФ-променів заслуговує окремої уваги, так як він свідчать про важливе значення механізмів репарації ДНК під час канцерогеннезу. Сонячне проміння може спричинити розвиток пухлин шкіри ( меланом, плоскоклітинних і базальноклітинних карцином). Немеланомні пухлини шкіри пов’язані із загальним кумулятивним впливом УФ-променів, тоді як виникнення меланом асоційоване зі значною короткочасно експозицією. УФ-промені спричиняють кілька біологічних ефектів на клітини. Найактуальнішою стосовно канцерогенизу є здатність до ушкодження ДНК шляхом утворенням піримідинових димерів; таке ушкодження відновлюється завдяки експозиції нуклеотидів. У разі інтенсивної експозиції УФ-випромінювання репаративних механізмів може бути недостатньо, і тому виникає пухлина. Як вже згадувалося, при пігментній ксеродермі репарація порушується шляхом експозиції нуклеотидів. Можна передбачити, що в таких осіб підвищений рівень схильності до розвитку онкологічних захворювань.
Пухлини судин: гістологічна класифікація, клініко-морфологічна характеристика, прогноз.
1.Кровоносних судин
Доброякісні:
Гемангіома

Доброякісна гемангіоперицитома
Гломусна пухлина
Злоякісні:
Ангіосаркома - злоякісна гемангіоендотеліома - злоякісна гемангіоперицитома
2. Лімфатичних судин
Доброякісні:
Лімфангіома
Злоякісні:
Лімфангіосаркома
Гемангіома – збірне поняття, яке включає новоутворення дисембріопластичного і бластоматозного характеру.
Капілярна гемангіома - характеризується утворенням атипових капілярів. Локалізується найчастіше у шкірі, іноді – у слизовій шлунково-кишкового тракту. Макроскопія: нагадує вузол із червоно-синьою, гладенькою або бугристою поверхнею. Мікроскопія: подубована з гіллястих судин капілярного типу з вузькими просвітами, характерна багатоядерність ендотеліальних клітин. Строма пухка або грубоволокниста.
Венозна гемангіома має вигляд вузла, складається з судинних порожнин різних розмірів, стінки яких вміщують гладком’язові пучки і нагадують вени; найчастіше розташовуються у глибині м’яких тканин.
Кавернозна гемангіома складається із судинних порожнин, трапляється найчастіше у печінці, шлунково-кишковому тракті. Макроскопія: має вигляд чітко відмежованого червоно-синього вузла, що нагадує губку. Мікроскопія складається із тонкостінних каверн, вистелених одним шаром ендотелію та заповнених кров’ю.
Артеріальна гемангіома являє собою конгломерат дефектно розвинених судин артеріального типу.
Доброякісна гемангіоперицитома – пухлина з кровоносних судин з переважною локалізацією в шкірі та міжм’язових прошарках кінцівок. Побудована з хаотично розташованих капілярів, оточених муфтами з проліферуючих перицитів; між клітинами – багата сітка агрофільних волокон.
Гломусна пухлина (Гломусангіома, пухлина Барре-Массона) – доброякісна пухлина мезенхімального походження, що складається із клітин, котрі нагадують модифіковані гладком`язові клітини нормального глобусного тільця. Переважно локалізується на кистях та стопах в області нігтьового ложа. Клінічно характеризується вираженим больовим синдромом у зв’язку з наявністю великої кількості нервових закінчень.
Макроскопія: виділяють солітарну та множинну дисеміновану (сімейну) гломусангіому. Найчастіше має вигляд одиничного вузла діаметром до 0,8 см, м’якої консистенції, сірувато-рожевого кольору. Мікроскопія: гломусангіома складається із судин, вистелених ендотелієм та оточених муфтою із епітеліоїдних клітин, що нагадують глобусні клітини.
Міоперицитома – пухлина судинного походження, що складається із овальних та веретеновидних клітин, що нагадують міоцити, та ростуть концентрично навколо судинних щілин. Переважно локалізуються у дермі та підшкірній клітковині нижніх кінцівок, голови та шиї, рідко – у м’яких тканинах. Клінічно здебільшого безсимптомна. Злоякісний варіант трапляється дуже рідко.
Злоякісна гемангіоендотеліома – агресивна пухлина, що локалізується найчастіше у шкірі та м’яких тканинах. Макроскопія: являє собою вузол часточкової будови, місцями з інфільтративним ростом; розрізі червоно-рожева, із вогнищами некрозів. Мікроскопія: пухлина побудована із безладно розташованих атипових судин, вистелених декількома шарами атипових ендотеліальних клітин із вираженим поліморфізмом та гіперхромними ядрами. Метастазує гемангіоендотеліома переважно у кістки, легені, печінку.
Злоякісна гемангіоперицитома – схожа на гемангіоендотеліому, але складається з атипових клітин періоцитарного характеру.
Лімфангіома – локалізується переважно у області шиї, слизовій оболонці рота, брижі, за очеревинному просторі. Розрізняють такі варіанти лімфангітом: кавернозна лімфангіома, кістозна гігрома, lymphangiomacircumscriptum, набута прогресуюча лімфангіома (синонім – лімфангіоепітеліома). Макроскопія: нечітко окреслене утворення у шкірі або підшкірній жировій клітковині. Мікроскопія: представлена численними лімфатичними судинами, заповненими лімфою, та вистеленими ендотелієм, що не виявляє ознак цитологічної атипії.
Лімфангіосаркома представлена лімфатичними щілинами з проліферуючими атиповими ендотеліальними клітинами.
Пухлини м'язової тканини: гістологічна класифікація, клініко-морфологічна характеристика, прогноз.
1.Доброякісні
• Лейоміома
• Рабдоміома
• Зернисто-клітинна пухлина
2. Злоякісні
• Лейоміосаркома
• Рабдоміосаркома
• Злоякісна зернисто-клітинна пухлина
Лейоміома– доброякісна тканина із гладких м’язів. Локалізується переважно у шкірі, матці, шлунково-кишковому тракті.
Макроскопія: щільний, чітко відмежований вузол; на розрізі волокнистий.
Мікроскопія: різнонаправлені пучки гладком`язових клітин.
При наявності вираженого фіброзного компоненту її називають фіброміомою, при наявності судинного компоненту – ангіолейоміомою.
Найбільше клінічне значення мають лейоміоми матки, що за локалізацією відносно шарів матки поділяють на субсерозні, інтрамуральні та субмукозні.
Лейоміосаркома – злоякісна пухлина із гладких м’язів. За ступенем диференціації поділяється на:
• високо- (мікроскопічно нагадують лейоміоми)
• низькодиференційовані (значно виражений поліморфізм, високе число мітозів)
Макроскопія: вузол, на розрізі вогнища крововиливів, некрозу, кістозних змін,
часто із інфільтрацією оточуючих тканин.
Мікроскопія: складається із веретеновидних клітин із відносно вираженим ядерним поліморфізмом та гіперхромією, високим проліферативним індексом.
Найчастіше зустрічається у заочеревинному просторі та порожнині тазу; можуть траплятися у на кінцівках, під шкірою, у стінці вен, рідше – артерій. Клінічно може проявлятися симптомами компресії порожнистих органів: синдром Бадда-Кіарі (у разі стиснення печінкових вен), набряк нижніх кінцівок (за рахунок стиснення судин), тощо.
Прогноз залежить від кількості мітозів.
Рабдоміома - доброякісна пухлина із поперечнопосмугованих м’язів. Зустрічається рідко, переважно у дітей.
Макроскопія: вузол або інфільтрат.
Мікроскопія: клітини рабдоміоми нагадують м’язові клітини різного ступеню диференціювання, у яких іноді виявляється поперечна посмугованість, (нагадують ембріональні м’язові волокна і міобласти).
Рабдоміосаркома – злоякісна пухлина із поперечнопосмугованих м’язів. Зустрічаються переважно у дітей. Локалізується у товщі м’язів нижніх, рідше – верхніх кінцівок, заочеревинно, у органах сечостатевої системи, на обличчі, шиї, тощо. Гістологічно розрізняють види:
• ембріональна,
• альвеолярна
• плеоморфна
Макроскопія: пухлини, що ростуть у порожнину тіла або органу, є досить чітко окресленими; на розрізі часто із вогнищами некрозу та кістами. Пухлини, що ростуть у м’язах, значно гірше відмежовані, часто інфільтрують прилеглі тканини.
Мікроскопія: характерний поліморфізм, обумовлений тим, що пухлинні клітини повторюють будову зародкових м’язових клітин на різних етапах ембріогенезу, характерні веретено-ракеткоподібні гігантські клітини, внутрішньоклітинні фібрили із посмугованістю чи без неї.
Прогноз дуже поганий.
Зернисто-клітинна пухлина ( пухлина Абрикосова) – найчастіше локалізується у язіку, шкірі, стравоході.
Макроскопія: має форму вузла, 2-3 см в діаметрі, контури нечіткі, капсули немає. У рідкісних випадках пухлина буває мультифокальною, одночасно вражаючи шкіру, слизові оболонки і внутрішні органи. На розрізі пухлина соковита, білястого або сіро-жовтого кольору. У великих вузлах можуть бути крововиливи і ділянки некрозу.
Мікроскопія: субепітеліальні розростання з великих овальних, округлих або полігональних клітин з чіткими контурами, з центрально розташованими круглими, іноді пікнотичних ядрами з сітчастою структурою хроматину, цитоплазма еозинофільна дрібнозерниста, багата глікогеном. Клітини розташовуються у вигляді осередків або компактно. Строма ніжна, колагенові волокна утворюють осередки, оточують дрібні комплекси пухлинних клітин, судин небагато.
Пухлини системи кровотворення: гістологічна класифікація, клініко-морфологічна характеристика, прогноз.
Пухлини кровотворної тканини називаються - гемобластози.
Вони підрозділяються на 2 групи:
1.системні або лейкози
2.регіонарні або лімфоми.
Лейкоз - це пухлина із кровотворної тканини, коли пухлина первинно виникає на "території" кісткового мозку.
При лімфомах первинно пошкоджуються регіонарні лімфоїдні утворення (Нр.: лімфатичні вузли), а кістковий мозок може пошкоджуватись потім в результаті метастазування.
1.За ступенем диференціації пухлинних клітин виділяють:
недиференційовані,
бластні
цитарні лейкози.
Гострі - як правило виникають коли в кістковому мозку розростаються недиференційовані клітини (клітини 1-3 класів) або бластні клітки (4 клас).
Хронічні лейкози (більше зрілі клітини - 5го й 6го класу)
2.За гістогенезом тобто залежно від виду клітин до гострих лейкозів відносяться:
Недиференційований
Міелобластний
Лімфобластний
Монобластний
Плазмобластний
Эритроміелобластний
Мегакаріобластний.
3.Хронічні лейкози підрозділяються за походженням на:
Лімфоцитарні
Мієлоцитарні
Моноцитарні
4.У свою чергу кожна з наведених груп лейкозів включає:
А.Мієлоцитарного походження:
Хр.мієлоидний лейкоз
Еритро-Мієлоидний
Еритремія
Щира поліцитемія
Б. Лімфоцитарного походження:
Хр.лімфолейкоз
Лімфоматоз шкіри (хвороба Сезарі)
Парапротеїнемічні лейкози.
В.Лейкози моноцитарного походження діляться на
Хр.моноцитарний
Гістіоцитози Х.
Хронічні лейкози характеризуються більш доброякісним і тривалим плином, що характеризується періодами ремісій і загострень. Тривалість плину деяких хронічних лейкозів може обчислюватися десятком років.
5.Залежно від кількості лейкоцитів у периферичній крові ділять на:
Лейкемічні лейкози (більше 50—80 • 109/л лейкоцитів у тому числі бластів),
Сублейкемічні (50—80 • 109/л, у тому числі бласти)
Алейкемічні (вміст лейкоцитів у периферичній крові нижче норми, бласти відсутні)
Лейкопенічні (вміст лейкоцитів у периферичній крові нижче норми, але є бласти).
Гострий лімфобластний лейкоз – новоутворення, що складається з незрілих В і Т лімфоцитів (лімфобластів). Мікроскопія: кістковий мозок гіперклітиний і переповнений лімфобластами, що є мієлопероксидазо негативними, мають поодинокі гранули глікогену, ядра з тонким конденсованим хроматином, мала кількість базофільної цитоплазми.
Макроскопія: соковитий, малинового кольору кістковий мозок з дрібними білими вкрапленнями. («малиновий кістковий мозок»).
Прогноз: стійка ремісія для дітей віком 2-10 років виникає у 80% випадків, інші вікові групи мають менш сприятливий прогноз
Гострий мієлобластний лейкоз – складається з бластів мієлоїдного ряду ( більше 20% у крові).
Макроскопія: кістковий мозок має картину «піоїдного», він соковитий, має зеленуватий колір, нагадує гній, але не має запаху.
Мікроскопія: кістковий мозок гіперклітинний і переповнений мієлобластами, шо мають азурофільні цитоплазматичні гранули та мієлопероксидазо позитивні.
Прогноз несприятливий, виживанісь складає 15-50% залежно від форми
Хронічний лімфоїдний лейкоз – неактивна пухлина з повільним ростом, що складається зі зрілих В- лімфоцитів.
Морфологія: згладжена архітектоніка лімфовузлів малими лімфоцитами з темним ядром , мають центри проліферації.
Хронічний мієлоїдний лейкоз – збільшена кількість лейкоцитів. У крові переважно циркулюють нейтрофіли, метамієлоцити і мієлоцити, базофіли і еозинофіли. Гіперклітиний кістковий мозок.
Класифікація лімфом:
Ходжкінські
Класичні варіанти:
Нодулярний склероз
Змішаноклітинний
Багатий лімфоцитами
Із придушенням лімфоїдної тканини
Із переважанням лімфоїдних клітин
Неходжкінські
- Фолікулярна лімфома
- Дифузна В-крупноклітинна лімфома
- Лімфома мантійної зони
- Лімфома Беркіта
- Плазмоцитарні неоплазії
Характеристика лімфом у питаннях спец. патоморфології.
Тератоми: визначення, епідеміологія, гістологічна будова, прогноз.
Тератоми - герміногенні експансивно зростаючі пухлини, що складаються з похідних трьох зародкових листків з наявністю або відсутністю елементів екстраембріональних тканин (елементів трофобласта); пухлини, що складаються з безлічі тканин, чужорідних в даній локалізації.
Класифікація тератом:
доброякісні: зрілі та незрілі
злоякісні
Зрілі тератоми - доброякісні високодиференційовані пухлини, Мікроскопія: зріла нейроглія, кістки, хрящ, волосся, гепатоцити, ГМК і поперечно-смугасті м'язи, інші зрілі соматичні структури, що походять з різних зародкових листків.
Незріла тератома - містить в повному обсязі незрілі соматичні структури, які відтворюють процеси органогенезу у ембріонів; Мікроскопія: незріла нейроектодерма з примітивними медулобластоподібними клітинами, нейробласти і нейробластомоподібні клітини, незрілі епітеліальна, ниркова і печінкова тканини, хрящ, примітивна мезенхіма, рабдоміобласти.
Злоякісна тератома - наявність незрілих тканин і карціноподобних солідних і папілярних структур, саркоматозних, ракових полів; швидко ростуть, рано метастазують в лімфатичні вузли , печінку, легені.
Епідеміологія: Згідно зі статистичними даними, тератома складає приблизно третину всіх пухлин у дитячому віці та 7 % пухлин у дорослих. Поширеність тератоми крижово-куприкової ділянки складає приблизно 1 випадок на 30 тисяч новонароджених, і вона є найбільш поширеною пухлиною серед новонароджених. У жінок тератома зустрічається частіше, ніж у чоловіків. Тератоми яєчника складають 25 % від усіх пухлин яєчника, і частіше зустрічаються у дорослому віці. Тератома яєчок є причиною близько 50 % випадків семіноми, та зустрічається з однаковою частотою у дітей та дорослих
Прогноз: У більшості випадків прогноз сприятливий, але в чималому ступені він залежить від того, в якому місці утворилася пухлина, наскільки своєчасною та адекватною було лікування. Тератома, протягом якої ускладнене деякими видами раку, протікає менш благополучно. У таких випадках навіть видалення тератоми та інших утворень не гарантує повного одужання.
Для яких пухлин типова клітинна та тканинна атіпія. Особливості обміну речовин в злоякісних пухлинах.
Тканинна атипія притаманна всім пухлинам, але у злоякісних вона більш виражена,в той час як клітинний атипізм притаманний тільки злоякісним пухлинам і характеризується ядерним поліморфізмом, збільшенням ядерно-цитоплазматичного співвідношення, посиленою базофілією ядра і цитоплазми.
Особливості метаболізму пухлинних клітин:
Виникає внутрішньоклітинний дисферментоз – одні ферменти загальмовуються, зате інші активуються або починають синтезуватися зовсім нові речовини, яких у нормальних клітинах не було.
Наявна уніфікація ізоферментного спектра пухлин незалежно від їх гістогенезу
Розвивається так звана монотонізація, або ізоферментне спрощення, – кількість ізоферментів зменшується, а їх набір стає приблизно однаковим для пухлини будь-якого походження. Ізоферментна перебудова іде в напрямку збільшення тих ферментів, які властиві ембріональним тканинам.
Найхарактерніші біохімічні особливості пухлинних клітин стосуються обміну білків і вуглеводів. Синтез білків переважає над їх розпадом. Для побудови власних білків пухлина захоплює амінокислоти з інших органів (“пухлина – пастка для азоту”).
Особливості енергетики пухлин: а) активація анаеробного гліколізу й ферментів, які його забезпечують, – піруваткінази, гексокінази, фруктокінази; б) наявність аеробного гліколізу, до якого нормальні клітини не здатні (винятки – лейкоцити, сперматозоїди, клітини сітківки ока); в) пригнічення дихання гліколізом (ефект Кребтрі), точніше потужною системою гліколітичних ферментів, які перехоплюють субстрати – неорганічний фосфор, коферменти.
Серед фізико-хімічних особливостей пухлинних клітин слід виділити такі: ацидоз внаслідок нагромадження молочної кислоти, внутрішньоклітинну гідратацію, нагромадження іонів калію, підвищення електропровідності, зменшення вязкості колоїдів, збільшення негативного заряду мембран, зменшення їх поверхневого натягу.
СПЕЦІАЛЬНА ПАТОМОРФОЛОГІЯ
Структура патологоанатомічного діагнозу.
1)Основне захворювання (основна причина смерті)- самостійна нозологічна форма, яка сама по собі (через ряд своїх проявів) або через ряд ускладнень призводить до функціональних розладів, що зумовлюють клініку хвороби і є причиною смерті.
Просте представлене однією нозологічною формою.
Комбіноване представлене двома або більше нозологічними формами:
Конкуруючі захворювання – дві самостійно однаково тяжкі хвороби, кожна з яких сама по собі (через ускладнення) могла призвести до смерті (наприклад, ІХС: інфаркт міокарда + рак легень).
Поєднані захворювання – наявність декількох несмертельних (по одинці) самостійних хвороб, які у поєднанні спричинюють потенціювання одне одного внаслідок спільної локалізації/патогенезу з виникненням загального (смертельного) ускладнення – “поліпатії” (ГХ + перелом стегна, що ускладнився бронхопневмонією, яка стала безпосередньою причиною смерті).
Фонові хвороби – хронічні самостійні нозологічні одиниці, що сприяють виникненню нових захворювань або розвитку несприятливого перебігу інших гострих захворювань (атеросклероз коронарних судин і інфаркт міокарда, цукровий діабет і септикопіємія).
2)Ускладнення (головне, другорядні) – несамостійні захворювання/патологічні процеси та стани, симптоми, синдроми, що патогенетично обумовлені основним захворюванням (або спричинені лікарськими маніпуляціями), що не є його проявом.
Головне (смертельне) ускладнення є безпосередньою причиною смерті.
3)Супутні захворювання – захворювання, ні етіологічно, ні патогенетично не пов’язане з основним захворюванням і його ускладненням, не вплинуло на їх розвиток і танатогенез. Воно не має ускладнень (хронічні захворювання у стані ремісії).
Визначення та приклади: основного захворювання.
Основне захворювання (основна причина смерті)- самостійна нозологічна форма, яка сама по собі (через ряд своїх проявів) або через ряд ускладнень призводить до функціональних розладів, що зумовлюють клініку хвороби і є причиною смерті.
Просте представлене однією нозологічною формою.
Приклад:
Хворий з постінфарктним кардіосклерозом помер від прогресуючої серцево-судинної недостатності, і в нього було виявлено рак пердміхурової залози без метастазів 1 стадії.
Діагноз:
Основне захворювання: ІХС: постінфарктним кардіосклероз, коронарний атеросклероз.
Ускладнення: Серцево-судинна недостатність
Супутні захворювання: Рак передміхурової залози 1 стадії.
Комбіноване представлене двома або більше нозологічними формами:
Конкуруючі захворювання – дві самостійно однаково тяжкі хвороби, кожна з яких сама по собі.
Приклад:
Одночасний розвиток на фоні гіпертонічної хвороби двох конкуруючих захворювань: великого трансмурального інфаркту міокарду, крововилив у головний мозок за типом гематоми.
Діагноз:
Комбіноване основне захворювання: Гострий трансмуральний інфаркт міокарду передньобічної стінки лівого шлуночка. Крововилив у ліву півкулю головного мозку.
Фонове захворювання: Гіпертонічна хвороба.
Ускладнення: Набряк легенів. Набряк та набухання речовини головного мозку.
Поєднані захворювання – наявність декількох несмертельних (по одинці) самостійних хвороб, які у поєднанні спричинюють потенціювання одне одного внаслідок спільної локалізації/патогенезу з виникненням загального (смертельного) ускладнення – “поліпатії”.
Приклад:
Поєднання ІХС: хронічної аневризми серця та бронхоекатичної хвороби, що призвело в сукупності до різко вираженої недостатності правого шлуночка.
Діагноз:
Комбіноване основне захворювання: ІХС: хронічна аневризма серця. Бронхоектатична хвороба.
Ускладнення: Легеневе серце. “Мускатна” печінка. Набряки, водянка порожнин.
Фонові хвороби – хронічні самостійні нозологічні одиниці, що сприяють виникненню нових захворювань або розвитку несприятливого перебігу інших гострих захворювань.
Приклад:
Діагноз при наявності флегмони шиї та цукрового діабету має бути сформульований таким чином.
Діагноз:
Основне захворювання: Флегмона шиї
Фонове захворювання: Цукровий діабет.
Визначення та приклади ускладнень основного захворювання.
Ускладнення - несамостійні захворювання/ патологічні процеси та стани, симптоми, синдроми, що патогенетично обумовлені основним захворюванням (або спричинені лікарськими маніпуляціями), що не є його проявами.
Ускладнення поділяться на головне та другорядні.
Головне (смертельне) ускладнення є безпосередньою причиною смерті.
Приклад 1
Основне захворювання: рак правої нирки
Головне ускладнення: загальна гіпопластична анемія
Другорядні ускладнення: множинні метастази в печінку, кахексія, венозне повнокрів'я селезінки, нирок; бура атрофія міокарду.
Приклад 2
Основне захворювання: рак тіла підшлункової залози з проростанням у стінку поперечної ободової кишки
Головне ускладнення: гостра постгеморагічна анемія
Другорядні ускладнення: метастази рака в печінку, канцероматоз черевної порожнини, бура атрофія серця, загальне виснаження; анемія легень, серця, нирок.
Визначення та приклади супутніх захворювань.
Супутні захворювання – це хвороби або патологічні процеси, які етіологічно та патогенетично не пов’язані з основним захворюванням або його ускладненнями, суттєво не впливають на його розвиток та ускладнення.
Приклад 1
Основне захворювання: цукровий діабет, тип II (інсуліно незалежний), декомпенсований.
Ускладнення: волога гангрена правої стопи, сепсис.
Супутнє захворювання: хронічний двобічний калькульозний пієлонефрит в стадії ремісії.
Приклад 2:
Основне (комбіноване) захворювання:
1) Iшемічна хвороба серця: повторний трансмуральний нижньобічний інфаркт міокарда. Стенозуючий атеросклероз коронарних артерій.
2) виразкова хвороба шлунка у стадії загострення: пенетруюча виразка в ділянці передньої стінки пілоричного відділу шлунка.
Ускладнення: гостре загальне повнокров'я внутрішніх органів. набряк легенів і головного мозку.
Супутні захворювання: атеросклероз аорти.
Приклад 3:
Основне захворювання:
Стенозуючий атеросклероз внутрішньої сонної артерії та артерій головного мозку. Ішемічний інсульт: сіре розм'якшення тканини головного мозку в лівій півкулі.
Ускладнення: Набряк мозку. Двобічна гіпостатична пневмонія. Дистрофія міокарда, нирок.
Супутні захворювання: Хронічний панкреатит. Катаральний атрофічний гастрит.
Варіанти комбінованого основного захворювання. Визначення та приклади.
Основне захворювання - це одна або декілька нозологічних одиниць (захворювань, травм), записаних в прийнятих в Міжнародній номенклатурі хвороб, МКБ-10 і вітчизняних класифікаціях термінах, які самі по собі або через обумовлені ними ускладнення привели до летального результату.
Основне захворювання може бути представлено двома і більше нозологічними одиницями і бути, отже, комбінованим (представленим конкуруючими, поєднаними, основним і фоновим захворюваннями).
Конкуруючі - захворювання, якими одночасно страждав померлий і кожне з них окремо безсумнівно могло призвести до смерті
Приклад: одночасні у одного хворого будь-які смертельні хвороби - рак IV стадії і інфаркт міокарда, несумісні з життям інфаркти головного мозку і міокарда.
Поєднані - захворювання, якими одночасно страждав померлий і, які, перебуваючи в різних патогенетичних взаєминах і взаємно обтяжуючи один одного, привели до смерті, причому кожне з них окремо не викликало б летального результату.
Приклад: поєднання нозологічних одиниць з груп гострих ішемічних хвороб серця та цереброваскулярних хвороб, які призвели до смерті лише в результаті взаємного обтяження. Таке ж поєднання нерідко характерно для цих же нозологічних одиниць з гострими хірургічними захворюваннями, зокрема, на виразкову хворобу шлунка або дванадцятипалої кишки.
Фонове - захворювання, яке етіологічно не пов'язане з основним, але включилося в загальний патогенез з основним захворюванням, стало одною з причин його розвитку, згодом обтяжувало перебіг і сприяло розвитку смертельних ускладнень, що призвели до летального результату.
Приклад: варіанти артеріальної гіпертензії або цукрового діабету для нозологічних одиниць з груп ішемічних хвороб серця та цереброваскулярних хвороб. Також нерідко такі захворювання, як алкоголізм, цукровий діабет, що ведуть до вторинного імунного дефіциту, стають фоновими для багатьох інфекційних хвороб (пієлонефрит, туберкульоз і ін.).
Приклади бікаузального діагнозу.
При бікаузальній формі діагнозу в ньому виставляється комбіноване основне захворювання. Комбіноване основне захворювання відображає поєднання двох провідних хвороб у хворого. Ці хвороби викликають новий патологічний стан і, взаємодіючи між собою, приводять до смерті (бікаузальний генез захворювання і смерті). При цьому дві нозологічні одиниці можуть перебувати в різних патогенетичних і танатологічних зв'язках.
Приклади:
1) Гострий трансмуральний інфаркт міокарда передньої і бічної стінок лівого шлуночка. Стенозуючий атеросклероз коронарних артерій серця.
2) Ішемічний інфаркт лобної долі правої півкулі головного мозку. Стенозуючий атеросклероз артерій головного мозку.
3) Ниркова артеріальна гіпертензія: ексцентрична гіпертрофія міокарда. Хронічний двосторонній пієлонефрит в фазі ремісії, пиелонефритическая нефросклероз.
Структура медичного заключення про причину смерті. Приклади.
Заповнення довідки про причину смерті провадиться шляхом підкреслювання, вписання необхідних відомостей та заповнення вічок відповідними позначеннями.
Заповненню підлягають усі пункти, при відсутності тих чи інших відомостей потрібно зазначити: "невідомо", "не встановлено".
1. ПІБ померлого
2. Вік померлого
3. Дата смерті
4. Причина смерті (основна причина смерті)
5. ПІБ лікаря, який видав довідку, дата, підпис лікаря
Пункт 9 лікарського свідоцтва про смерть (основна причина, внаслідок якої настала смерть) заповнюється відповідно до Міжнародної статистичної класифікації хвороб та споріднених проблем охорони здоров`я десятого перегляду (МКХ-10), де зазначається один з перелічених пунктів:
- захворювання
- неуточнені причини смерті
- нещасний випадок поза виробництвом, нещасний випадок у зв`язку з виробництвом
- навмисне самоушкодження
- наслідки нападу
- випадки ушкодження з невизначеним наміром
- ушкодження внаслідок дій, передбачених законом, та воєнних операцій
- ускладнення внаслідок терапевтичної та хірургічної допомоги
- віддалені наслідки зовнішніх причин захворюваності та смертності
У пункті 11 лікар указує свої прізвище, ім'я, по батькові, посаду і зазначає підставу, яка дає змогу визначити послідовність патологічних процесів, які призвели до смерті, і вказує причину смерті.
Основною (первинною) причиною смерті потрібно вважати хворобу або травму, що призвела до розвитку хворобливих процесів, які спричинили смерть, або наслідки нещасного випадку чи насильства, що стали причиною смерті.
У частині I пункту 11 у рядку "а" записується хвороба або стан, що безпосередньо призвела до смерті, у рядках "б", "в", "г" зазначаються патологічні стани (якщо такі були), що зумовили безпосередню причину смерті (згадану вище); основна причина смерті вказується в останню чергу. Під безпосередньою причиною смерті потрібно розуміти хворобу або стан, що безпосередньо викликали смерть.
У частині II свідоцтва записуються інші суттєві стани або захворювання, які сприяли настанню смерті, але не були пов'язані із хворобою чи станом, що безпосередньо призвели до смерті. У цьому пункті потрібно вказати дату операції, інфаркту міокарда, інсульту, термін вагітності, якщо такі мали місце.
Приклад 1:
I. а) Геморагічний шок б) Гостра крововтрата в) Розрив печінки (S36.1) г) Наїзд автобуса на пішохода на шосе (V04.1)
II. _________________________________________
Основна причина смерті повинна бути зашифрована - наїзд автобуса на пішохода на шосе (V04.1).
Приклад 2:
I. а) Перитоніт б) Розрив шлунка та поперечної ободової кишки (S36.3) в) Травмований пішохід (V09.3) г) __________________________________________________
II. _________________________________________________
Основна причина смерті - травмований пішохід (V09.3)
Анемії – визначення, класифікація, морфологія різних форм анемії.
Анемія – захворювання крові, які характеризуються зміною кількості еритроцитів або насичення їх гемоглобіном в одиниці об’єму крові. Одночасно в периферичній крові можуть з’являтися еритроцити різних розмірів- пойкілоцитоз, різної форми – анізоцитоз, різного ступеня забарвлення – гіперхромія та гіпохромія, еритроцити з включеннями – тільця Жолі, кільця Кабо, ядерні еритроцити – еритробласти, нормобласти, мегалобласти.
Класифікація за етіологією та патогенезом :
1) анемiї, що виникають на тлi порушеного кровотворення (дефiцитнi, апластичнi); 2) анемiї внаслiдок пiдвищеного руйнування еритроцитiв (гемолiтичнi); 3) анемiї, що пов’язанi з крововтратою (постгеморагiчнi).
Залежно від характеру перебігу: гострі та хронічні.
У відповідності до морфологічного та функціонального стану кісткового мозку, що відображає його регенераторні властивості, анемія може бути:
регенераторною
гіпорегенераторною
гіпопластичною
апластичною
дипластичною
Постгеморагічна анемія: етіологія, патогенез, патологічна морфологія.
Постгеморагічні анемії розвиваються внаслідок: масивної кровотечі з судин шлунка, кишечника при їх виразкуванні чи пухлинному ураженні, при розриві маткової труби внаслідок позаматкової вагітності, розриву аорти, роз’їданню судин легені туберкульозним процесом, тощо.
При кровотечі з великих судин розвивається гостра постгеморагічна анемія і смерть настає швидше, ніж розвиваються морфологічні прояви анемії. При тривалій кровотечі з дрібних судин виникає хронічна постгеморагічна анемія, яка проявляється блідістю шкіри, слизових оболонок, внутрішніх органів.
Патологічна анатомія гострої постгеморагічної анемії: Червоний кістковий мозок у плоских кістках, епіфізах гіперплазується,проліферує, стає яскравим, соковитим. Жовтий кістковий мозок метаплазується в червоний (багатий клітинами еритропоетичного та мієлоїдного ряду), з’являються осередки екстрамедулярного кровотворення в селезінці, тимусі, лімфатичних вузлах та інших тканинах.
Патологічна анатомія хронічної постгеморагічної анемії: шкіряні покриви і внутрішні органи бліді.В кістковому мозку трубчастих кісток спостерігаються явища регенерації з перетворенням жирового кісткового мозку в червоний; виникають множинні осередки позакістковомозкового кровотворення. Внаслідок гіпоксії у внутрішніх органах розвиваються дистрофічні зміни, дрібні крововиливи на слизових та серозних оболонках.
Гемолітична анемія: етіологія, патогенез, патологічна морфологія.
Гемолітичні анемії - значна група хвороб крові, при яких процеси кроворуйнування переважають над процесами кровотворення.
Характеризуються підвищеною руйнацією еритроцитів, яка може бути внутрішньосудинною та позасудинною. Внутрішньосудинні гемолітичні анемії виникають при попаданні в організм гемолітичних отрут, при тяжких опіках - токсичні анемії; при малярії, сепсисі та інших інфекціях – інфекційні анемії; при переливанні несумісної за групою чи резус-фактором крові – посттрансфузійні анемії; при імунопатологічних процесах – імунні , ізоімунні та аутоімунні анемії (гемолітична хвороба новонароджених, хронічний лімфолейкоз, карциноматоз кісткового мозку, системний червоний вівчак, медикаментозний імунний гемоліз, температурні гемоглобінурії та інш.). Позасудинні (внутрішньоклітинні) гемолітичні анемії переважно мають спадкове походження і розділяються на еритроцитопатії, еритроцитоферментопатії та гемоглобінопатії.
До гемолітичних анемій, які розвиваються внаслідок дефекту структури мембрани еритроцитів, відносять спадковий мікросфероцитоз, спадковий овалоцитоз та інш.
Еритроцитоферментопатичні гемолітичні анемії виникають при недостатності ферменту пентозофосфатного циклу – глюкозо-6-фосфатдегідрогенази та піруваткінази.Ці анемії прогресують при вірусних інфекціях, вживанні деяких медикаментів.
Гемоглобінопатичні гемолітичні анемії розвиваються при порушенні синтезу гемоглобіну - A- і B-таласемія чи при появі аномальних гемоглобінів – S, C, D, E. Серповидно-клітинна анемія може поєднуватися з іншими гемоглобінопатіями
Морфологічні прояви гемолітичних анемій в переважній більшості досить специфічні: загальний гемосидероз, надпечінкова або гемолітична жовтяниця з розвитком у важких випадках гемоглобінурійного нефрозу, спленомегалія при спадкових гемолітичних анеміях, наявність осередків екстрамедулярного кровотворення.Кістковий мозок реагує на руйнування еритроцитів гіперплазією і тому стає рожево-червоним .
При автоімунних гемолітичних анеміях у хворих існує порушення імунного статусу з детермінацією антигенних структур, що призводить до синтезу антитіл проти власних незмінених еритроцитів
Імунний гемоліз у дорослих звичайно викликаний IgG-антитілами або IgM-антитілами до антигенів власних еритроцитів — автоантитілами. Рідко спостерігається руйнування донорських еритроцитів алоантитілами.
Гемобластози – визначення, етіологія, патогенез та патоморфологія.
Гемабластози розподіляють на дві групи:
1)лейкози - системні пухлинні захворювання кровотворної тканини;
2)лімфоми - регіонарні пухлинні захв. кровотворної, лімфатичної тканини.
Етіологія та патогенез. У виникненні гемобластозів велике значення має вплив іонізуючого випромінювання (радіаційна теорія). Наслідки атомного бомбардування в Японії показали, що частота виникнення лейкемій прямо пропорційна дозі опромінення. Виражену бластомогенну активність мають ряд хімічних сполук та медикаментів: бензол, леткі органічні розчинники, левоміцетин, бутадіон, циклофосфан, мієлосан, лейкеран та інші, а також ряд метаболітів триптофану і тирозину, (при порушенні обміну цих амінокислот) – хімічна та ендогенна теорії.
В експерименті на тваринах отримані стверджуючі дані про значну роль вірусів у виникненні деяких форм гемобластозів у людини: Т-клітинної лейкемії та грибовидного мікозу дорослих (ретровірус НТLV – “вірус Т-клітинної лейкемії – лімфоми людини”), лімфоми Беркітта (вірус герпеса Епштейна-Бара). Дію вірусів може підсилювати спадковий чи набутий імунодефіцит, генетичні та гормональні чиннники, існують дані про можливий взаємозв’язок антигенів гістосумісності (HLA) з деякими формами гемобластозів.
Суттєве значення має вплив генетичних чинників (про це свідчать дані щодо виникнення лейкемій у однояйцевих близнюків). Доведено зростання ризику захворюваності при вроджених хромосомних аномаліях (синдроми Фанконі, Клайнфелтера, Дауна, Блума тощо). У 90-95% хворих на хронічну мієлоїдну лейкемію виявляють аномальну філадельфійську (Рh’) хромосому.
Пухлинна прогресія при гемобластозах характеризується клоновим походженням і підвищеною хромосомною мінливістю, що в свою чергу визначає мінливість властивостей пухлини. При прогресуванні захворювання спостерігається пригнічення нормальних паростків кровотворення. Подальше поширення гемобластозного клона здійснюється шляхом метастазування.
Лейкози – визначення, принцип класифікації, загальна характеристика.
Лейкози - системні пухлинні хвороби.
Класифікація:
Гострі (проліферація бластних клітин, злоякісність перебігу):
недиференційований
мієлобластний
лімфобластний
плазмобластний
монобластний
еритромієлобластний
мегакаріобластний
Хронічні (проліферація диференційованих клітин, доброякісність перебігу):
мієлоцитарного походження : мієлоїдний,еритромієлоз,еритремія,справжня поліцитемія.
лімфоцитарного походження : лімфолейкоз, лімфоматоз шкіри, парапротеїнемічні лейкози, мієломна хвороба, первинна макроглобулінемія, хвороба Тяжких ланцюгів.
моноцитарного походження: моноцитарний лейкоз,гістіоцитоз.
В залежності від ступеня підвищення чи зменшення в периферичній крові загальної кількості лейкоцитів, розрізняють:
Лейкемічні
Сублейкемічні
Лейкопенічні
Алейкемічні варіанти лейкозу
Лейкози характеризуються системнім прогресуючим розростанням кровотворних клітин пухлинного походження. Спочатку розростаються в органах кровотворення , потім гематогенним шляхом потрапляють в інші орг. та ткан і утвор лейкозні інфільтрати навкруги судин, в їх стінках. Дифузна інфільтр. призводить до збільш. органу або ткан., а осередкова – утворення пухлинних вузлів.
Етіологія лейкозів:
• Іонізуюча радіація • Хімічні канцерогенні речовини • Деякі види вірусів • Спадкова схильність до ракових захворювань • Набутий імунодефіцит • Медикаменти, до складу яких входять алкілуючі з'єднання • Побутові фактори (вихлопи автомобілів, добавки в різні харчові продукти, куріння) • Механічні пошкодження тканин
Патогенез пов’язують з активізацією протоонкогенів, що призводять до проліферації та диференціювання кровотворних кліт з подальшою злоякісною трансформацією. Мають вплив спадкові фатори.
Гострі лейкози – етіологія, класифікація, гострий недиференційований лейкоз клініко-анатомічна та патоморфологічна характеристика, наслідки.
Гострі лейкози (гострі лейкемії) — системні пухлинні хвороби. Група швидко прогресуючих захворювань, що характеризуються проліферацією найбільш молодих, недиференційованих стовбурових клітин червоного кісткового мозку, які втратили здатність до визрівання (диференціації).
Етіологія лейкозів:
• Іонізуюча радіація • Хімічні канцерогенні речовини • Деякі види вірусів • Спадкова схильність до ракових захворювань • Набутий імунодефіцит • Медикаменти, до складу яких входять алкілуючі з'єднання • Побутові фактори (вихлопи автомобілів, добавки в різні харчові продукти, куріння) • Механічні пошкодження тканин
Класифікація гострих лейкозів:
недиференційований
мієлобластний
лімфобластний
плазмобластний
монобластний (мієломонобластний)
еритромієлобластний (ді Гульєльмо)
мегакаріобластний
Гострий недиференційований лейкоз:
Ця форма характеризується інфільтрацією кісткового мозку,селезінки,лімфатичних вузлів, лімфоїдних утворень, стінок судин, нирок баластними клітинами. Кістковий мозок- червоний соковитий з сірим відтінком.
Виникає некротична ангіна , гінгівіт через лейкозну інфільтрацію слизової оболонки ротової порожнини.
Коли до лейкозу + вторинна інфекція,то лейкоз перебігає як септичне захворювання.
Наявний геморагічний синдром - лейкозні клітини руйнують стінки судин, розвиток анемії,порушення тромбоцитоутворення внаслідок заміщення кісткового мозку недиференційованими клітинами гомопоезу.
Крововиливи у шкірі, слизових оболонках,внутрішніх органах, в головному мозку.
Гострі лейкози – етіологія, класифікація, мієлобластний лейкоз клініко-анатомічна та патоморфологічна характеристика, наслідки.
(Визначення, етіологія, класифікація – див. питання №13.)
Гострий мієлобластний лейкоз (гострий мієлолейкоз) – при цій формі кістковий мозок, печінка, селезінка, нирки інфільтруються пухлинними клітинами мієлобластного ряду з цитохімічними властивостями (в них є глікоген, суданофільні включення; позитивна реакція на пероксидазу, хлорацетатеразу).
Кістковий мозок - червоний або сіруватий, іноді набуває гноєвидного відтінку (піоїдний кістковий мозок).
Селезінка, печінка, лімфатичні вузли збільшуються внаслідок лейкозної інфільтрації.
Бластні клітини наявні в слизовій оболонці шкт виникають некрози в ротовій порожнині, мигдаликах, зеві.
В нирках – дифузні чи осередкові пухлинні інфільтрати.
В 1/3 випадків розвивається лейкозна інфільтрація легень («лейкозний пневмоніт»); в 1/4 випадків – лейкозна інфільтрація мозкових оболонок («лейкозний менінгіт»); різко виражений геморагічний діатез.
Крововиливи спостерігаються в слизових і серозних оболонках, внутрішніх органах. Помирають хворі від кровотеч, некротично-виразкових ускладнень, приєднаної інфекції, сепсису.

Гострі лейкози – етіологія, класифікація, промієлоцитарний лейкоз клініко-анатомічна та патоморфологічна характеристика, наслідки.
Гострий промієлоцитарний лейкоз- відрізняється гостротою перебігу,злоякісністю та значним геморагічним синдромом(тромбоцитопенія,гіпофібриногенемія).лейкозні клітини,що інфільтрують органи і тканини,мать такі морф.особливості: ядерний і клітинний поліморфізм,скопичення в плазмі псевдоподій і гранул глікозамінгліканів.
Гострі лейкози – етіологія, класифікація, лімфобластний лейкоз клініко-анатомічна та патоморфологічна характеристика, наслідки.
Гострий лімфобластний лейкоз –частіше зустріч у дітей.
Лейкемічні інфільтрати переважають в кістковому мозку,лімф вузлах,лімф апараті шкт,селезінці,нирках,вилочко вій залозі.
Кістковий мозок-малиново-червоний,соковитий.Значно збільшені лімфатичні вузли за рахунок інфільтрації їх лімфобластними клітинами;на розтині вони біло-рожеві,соковиті.Іноді лейкозний інфільтрат виходить за межі залози і розповсюджується на переднє середостіння,здавлюючи органи грудної порожнини.
Лейкозні інфільтрати складаються з лімфобластів,де скопи чуються глікоген навколо ядра.Лімфобласти з Т системи .
Ознака прогресування лейкозу-лімфобластні інфільтрати метастатичного походження.Особливо часто такі інфільтрати зустріч в оболонках та речовині спинного мозку,що називають нейролейкозом.
Гострий лімфобластний лейкоз – злоякісне захворювання системи кровотворення, що характеризується неконтрольованою проліферацією незрілих лімфоїдних клітин (лімфобластів).
Етіологія:
--спадкові(різні синдроми )
--хімічні сполуки
--радіоактивне випромінювання
--гемолітичні розлади
Патологоанатомічні зміни: Кістковий мозок-малиново-червоний,соковитий.Значно збільшені лімфатичні вузли за рахунок інфільтрації їх лімфобластними клітинами;на розтині вони біло-рожеві,соковиті.
Наслідки: метастази переважають в кістковому мозку,лімф вузлах,лімф апараті шкт,селезінці,нирках,вилочковій залозі.
Лейкозні інфільтрати складаються з лімфобластів,де скопи чуються глікоген навколо ядра.Ознака прогресування лейкозу-лімфобластні інфільтрати метастатичного походження.Особливо часто такі інфільтрати зустріч в оболонках та речовині спинного мозку,що називають нейролейкозом.
Гострі лейкози – етіологія, класифікація, плазмобластний та монобластний лейкози, клініко-анатомічна та патоморфологічна характеристика, наслідки.
Гострий плазмобластний лейкоз- форма лейкозу,що виникає з клітин попередників-лімфоцитів,що продукують імуноглобуліни;і в пухлинних плазмобластах. В них утвор і виділяються патологічні імуноглобуліни –парапротеїни, а отже цей лейкоз відноситься до парапротеїнемічних гемобластозів.Значна кількість плазмобластів виявляється в периферичній крові.
Гострий монобластний лейкоз-майже не відріз від мієлобластного.
Гострі лейкози – етіологія, класифікація, ерітромієлобластний та мегакаріобластний лейкози, клініко-анатомічна та патоморфологічна характеристика, наслідки.
Гострі лейкози (гострі лейкемії) — системні пухлинні хвороби. Група швидко прогресуючих захворювань, що характеризуються проліферацією найбільш молодих, недиференційованих стовбурових клітин червоного кісткового мозку, які втратили здатність до визрівання (диференціації).
Етіологія лейкозів:
• Іонізуюча радіація • Хімічні канцерогенні речовини • Деякі види вірусів • Спадкова схильність до ракових захворювань • Набутий імунодефіцит • Медикаменти, до складу яких входять алкілуючі з'єднання • Побутові фактори (вихлопи автомобілів, добавки в різні харчові продукти, куріння) • Механічні пошкодження тканин
Класифікація гострих лейкозів:
недиференційований
мієлобластний
лімфобластний
плазмобластний
монобластний (мієломонобластний)
еритромієлобластний (ді Гульєльмо)
мегакаріобластний
Гострий еритромієлобластний лейкоз- рідкісна форма,при якій в кістковому мозку відбувається розростання як еритробластів та інших ядерних клітин еритропоезу,так і мієлобластів,монобластів і недиференційованих бластів. Внаслідок пригнічення кровотворення виникають анемія,лейко і тромбоцитопенія;селезінка та печінка при цьому збільшуються.
Гострий еритромієлобластний лейкоз (гострий ертиромієлоз ді Гульєльмо).
Це досить рідкісна форма (1-3%) серед всіх форм гострих лейкозів, при якій в кістковому мозку відбувається розростання як еритробластів та інших ядерних клітин еритропоезу, так і мієлобластів, монобластів і недиференційованих бластів. Внаслідок пригнічення кровотворення виникають анемія, лейко- і тромбоцитопенія; селезінка та печінка при цьому збільшуються.
Гострий мегакаріобластний лейкоз.
Одна із найбільш рідкісних форм гострого лейкозу, для якої характерна присутність в крові і кістковому мозку поряд з недиференційованими бластами також мегакаріобластів, спотворених мегакаріоцитів та скопичень тромбоцитів; кількість тромбоцитів в крові підвищується до 1000-1500 * 109 /л
Хронічні лейкози мієлоцитарного походження – визначення, різновиди, хронічний мієлоїдний лейкоз: клініко-анатомічна та патоморфологічна характеристика, наслідки.
Хронічні лейкози – системні пухлинні хвороби кровотворної тканини, що характеризуються наростанням числа «нормальних», або близьких до «нормальних» по зрілості клітин. Проте процеси проліферації в даному випадку не контролюються і аномальні лінії заповнюють кістковий мозок.
Етіологія і патогенез:
Гемобластози асоціюються із мутаціями, що блокують дозрівання клітин, або зменшують їх залежність від факторів росту. Це зумовлює моноклональну експансію гемопоетичних елементів, які заміщують нормальні клітини кісткового мозку. Найчастішим варіантом таких мутацій для лейкозів є транслокація.
Онковіруси
Екзо-/ендоканцерогени
Опромінення
Соматична мутація клітин попередниць кровотворної тканини
Поркушення проліферації клітин із збереженням диференціювання
Вторинні мутації, що пов’язані з нестабільністю геному
Накопичення маси пухлинних клітин
Пригнічення нормального кровотворення
Прогресія пухлинного клону
Метастазування в тканини і органи
Анемічний, геморагічний, імунодефіцитний стани
Повний розлад регуляції, резистентність до терапії.
Хронічні лейкози мають доброякісний перебіг, що може тривати роками, проте накопичення бластних форм зумовлює перехід у гостру форму.
Класифікація.
Хронічні лейкози
Лімфоцитарні:
1.Хронічний лімфолейкоз.
2.Лімфоматоз шкіри (хв. Сазарі).
3.Парапротеїнемічні лейкози:
мієломна хв.
первинна макроглобулінемія
хв. тяжких ланцюгів.
Моноцитарні:
1.Хронічний моноцитарний лейкоз.
2. Гістіоцитози.
Мієлоцитарні
1.Хронічний мієлоїдний лейкоз.
2.Хронічний еритромієлоз.
3.Еритемія.
4.Справжня поліцитемія.
Відповідно до схеми гемопоезу хронічні лей роки класифікують за походженням на:
Хронічні лейкози мієлоцитарного походження – визначення, різновиди, хронічний еритромієлоз, еритремія та справжня поліцитемія: клініко-анатомічна та патоморфологічна характеристика, наслідки.
+
Хронічні лейкози лімфоцитарного походження – визначення, різновиди, хронічний лімфолейкоз та лімфоматоз шкіри: клініко-анатомічна та патоморфологічна характеристика, наслідки.